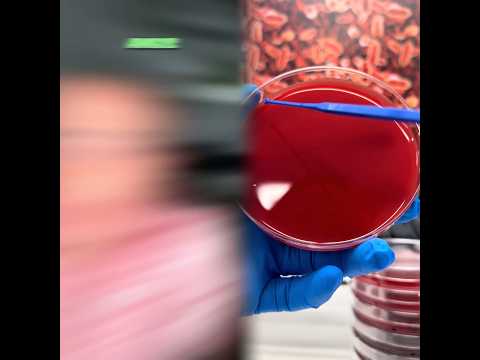
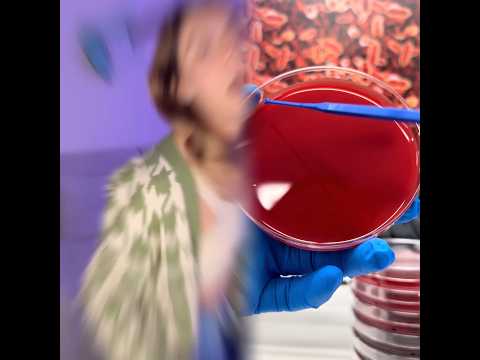

Channel Overview
Lennis Ayarza, a top YouTuber , boasts 50.1K subscribers, 27.2M views and ranks #298029 globally . The channel recently hit 7.0M views in last 28 days.
- Channel:Lennis Ayarza
- Subscribers:50.1K
- Views:27.2M
- Videos:44
- 28 days views:7.0M
- Global Rank:#298029
Lennis Ayarza Channel Stats
Updated: 13 Apr
50.1K
27.2M
1.1K
44
618.0K
--
3 months ago
3
Advanced Analytics
Channel Daily Performance
Channel Videos
Trending Videos
Lennis Ayarza Channel Rank
Subscribers
50,100
Views
27,190,446
Subs (28 Days)
Views (28 Days)
Lennis Ayarza Latest Videos

00:49
This is so funny, l couldn't stop laughing #funny #funnyvideos#duet #foryou #humor #viralvideo
Lennis Ayarza
726.3K
+4.6K
6.7K
23 Feb 2026

00:44
This is so funny, l couldn't stop laughing #funny #funnyvideos#duet #foryou #humor #viralvideo
Lennis Ayarza
1.1M
+10.2K
8.4K
20 Feb 2026
00:38
This is so funny, l couldn't stop laughing #funny #funnyvideos#duet #foryou #humor #viralvideo
Lennis Ayarza
3.4M
+2.8K
30.5K
19 Feb 2026

00:47
This is so funny, l couldn't stop laughing #funny #funnyvideos#duet #foryou #humor #viralvideo
Lennis Ayarza
133.5K
+150
1.9K
16 Feb 2026
01:00
This is so funny, l couldn't stop laughing #funny #funnyvideos#duet #foryou #humor #viralvideo
Lennis Ayarza
238.5K
+37
1.6K
12 Feb 2026
Lennis Ayarza Latest Trending Videos



